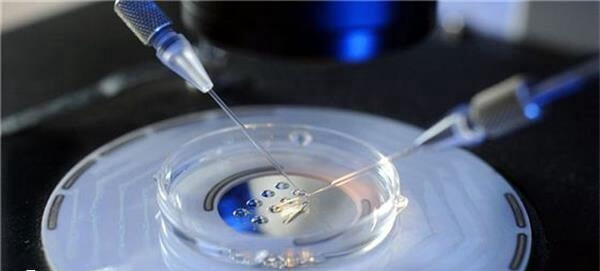
试管短方案可以鲜胚移植

试管婴儿短方案促排后当月可以进行鲜胚移植吗?
发布:2025-09-30 19:01:51
浏览128次
问题描述:
一般情况下,试管短方案是可以鲜胚移植的,但决定是否进行鲜胚移植的并不是女性患者的主观选择,而是由医生根据女性患者在取卵手术后的子宫和卵巢情况来进行决定的,如果在鲜胚移植前女性的身体情况达到了可以进行移植的标准,则就可以进行鲜胚移植,但如果没有达到要求,或者是有出现卵巢过度刺激综合征的表现,则就需要进行冻胚移植,等到身体情况达到了移植标准后才可以移植。
最佳答案
一般情况下,试管短方案是可以鲜胚移植的,但决定是否进行鲜胚移植的并不是女性患者的主观选择,而是由医生根据女性患者在取卵手术后的子宫和卵巢情况来进行决定的,如果在鲜胚移植前女性的身体情况达到了可以进行移植的标准,则就可以进行鲜胚移植,但如果没有达到要求,或者是有出现卵巢过度刺激综合征的表现,则就需要进行冻胚移植,等到身体情况达到了移植标准后才可以移植。
试管短方案鲜胚移植的条件
不管是试管的促排卵方案还是最后的移植方案,都是由医生根据女性患者的身体情况来进行决定的,而部分使用试管短方案的女性患者也是可以进行鲜胚移植的,但需要满足以下条件。
- 1. 鲜胚移植前需要检测女性体内雌激素、孕激素等,只要数值正常达到了平衡才可以移植,如果女性体内的孕酮数值偏低的话,则在移植鲜胚后容易发生宫缩,可能会出现把鲜胚排出体外的现象;
- 2. 卵巢功能正常的女性才可以进行鲜胚移植,不管是什么促排卵方案,在取卵手术前都需要使用到促排卵药物,会导致卵巢出现肿大的情况,从而影响到卵巢的功能;
- 3. 子宫内膜厚度在8-13mm左右比较合适进行鲜胚移植,如果女性的子宫内膜太薄的话,不利于胚胎着床,会导致移植失败。
总的来讲,试管短方案是可以进行鲜胚移植的,但需要同时满足卵巢功能正常、体内激素水平平衡以及子宫内膜厚度在8-13mm左右的时候,才可以进行鲜胚移植,有出现其中一项没有达到标准的情况时,则很可能会导致移植失败,如果有像这位女性患者一样,想要缩短试管婴儿治疗的周期时间,就可以服用恢复类的药物来加速身体情况的恢复,需要注意的是,药物因由患者的主治医生进行配置,禁止自己私下用药。
好孕交流群 分享心理 链接关系 共同目标
最新问题
- 连云港三院做试管婴儿怎么样?冻胚移植成功率高吗? 2026-04-17
- 吉林市做试管婴儿需要多少钱?一代4万元够吗? 2026-04-17
- 试管婴儿成功后,需要一直做保胎治疗吗?保胎多久可以停止? 2026-04-17
- 做试管婴儿,男方需要戒烟戒酒多久?偶尔抽烟喝酒有影响吗? 2026-04-17
- 阜阳人民医院能做试管婴儿吗?成功率有多高? 2026-04-16
- 安徽蚌埠有做试管婴儿的医院吗?蚌医一附院能做吗? 2026-04-16
热点问题榜
网友关注的问题
排名
主题
阅读量
-
13263 -
212415
-
311763
-
411427
-
511338
-
611185
-
710997
-
810814
-
910741
-
1010021
热门资讯
助您好孕多多
医院




